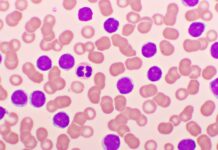
AMPLIFY Trial Reports Results of Acalabrutinib-Venetoclax in TN-CLL

A study presented atthe ASH Annual Meeting indicates that β-hydroxybutyrate (BHB), the principal metabolite produced during ketosis, augmented the function of chimeric antigen receptor (CAR) T-cell therapy in a mouse model of cancer. The researchers plan a first-in-human clinical trial of BHB-supplementation in patients receiving CAR T-cell therapy for relapsed or refractory B cell lymphoma.
“Several mechanisms of resistance have been identified for CAR T-cell therapy; however, there are limited data on the impact of lifestyle factors, such as diet, on CAR T-cell efficacy,” wrote the authors, led by Shan Liu, of the Department of Microbiology at the University of Pennsylvania in Philadelphia. “Indeed, diet-derived metabolites can modulate T-cell functions through the regulation of metabolic, epigenetic, and transcriptional processes.”
The researchers implanted diffuse large B-cell lymphoma (DLBCL) tumors into immunocompetent mice. They then fed the mice one of five diets: ketogenic, high fiber, high fat, high protein, high cholesterol, and a control diet. Next, they treated the mice with CAR T-cell cells. The mice that received a ketogenic diet showed improved tumor control and overall survival compared with the other tested diets. As the researchers had expected, BHB was significantly higher in the ketogenic mice.
“Since effector T cells can utilize BHB to fuel the citric acid cycle, we hypothesized that BHB can serve as a more efficient energy source than glucose for active CAR T cells, leading to more pronounced effector responses,” they wrote. Therefore, they tested the effects of BHB alone on several mouse cancer models.
In mice with DLBCL tumors, those receiving oral BHB demonstrated better tumor control than controls (complete response [CR] in 6 of 7 versus 1 of 7). BHB-treated mice also had higher peripheral CAR T-cell expansion and higher levels of serum effector cytokines. In addition, the results showed better tumor control for pancreatic cancer and B-cell acute lymphoblastic leukemia.
The authors reported that BHB serum concentration was positively correlated with CAR T-cell expansion. “The key mechanism involves the enhancement of the citric acid cycle and histone modifications during CAR T-cell activation,” the authors concluded.
https://ash.confex.com/ash/2024/webprogram/Paper208913.html
Reference
Liu S, Guruprasad P, Han K, et al. Ketogenic diet enhances CAR T cell antitumor function via β-hydroxybutyrate. Abstract #4. Presented at the 66th American Society of Hematology Annual Meeting and Exposition; December 7–10, 2024; San Diego, California.